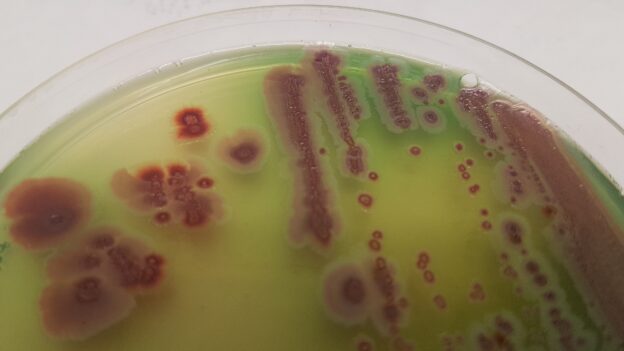

RAPID CETRIMIDE RAPID CROMOGENIC AGAR (BASE)
Medio cromogénico selectivo para la detección rápida de Pseudomonas aeruginosa
Basado en el medio farmacopéico USP “Medium N”
Detección en las primeras 18–24 horas en productos farmacéuticos y cosméticos (USP, ISO 22717)

COMPOSICIÓN (por litro)
| Componente | Cantidad |
|---|---|
| Peptona pancreática de gelatina | 20,0 g |
| Cetrimida | 0,3 g |
| Cloruro magnésico | 1,4 g |
| Sulfato dipotásico | 10,0 g |
| Mezcla cromogénica | c.s. |
| Agar-agar | 13,6 g |
pH final: 7,2 ± 0,2
PREPARACIÓN
-
Disolver 44,5 g del medio en 1 litro de agua destilada.
-
Añadir 10 ml de glicerol.
-
Calentar hasta ebullición, agitando constantemente hasta la disolución completa.
-
Autoclavar a 121 ºC durante 15 minutos. No sobrecalentar.
-
El medio final es blanquecino, pudiendo presentar tonalidades rosadas tras la autoclave que desaparecen tras la oxigenación al vertirlo en placas.
Para uso exclusivo en laboratorio.
Agite el bote antes de usar.
Mantenga el bote bien cerrado, en lugar seco, fresco y oscuro.
Código del medio deshidratado: DMT550
CONTROL DE CALIDAD DEL MEDIO
El control se realiza en nuestro laboratorio. Se recomienda repetirlo en su laboratorio siempre que varíen las condiciones de almacenamiento o manipulación (por ejemplo, más de 3 meses sin uso, tras desinfección, exposición a altas temperaturas o cambios de aspecto).
Aspecto del medio:
-
Deshidratado: Polvo grueso, blanco.
-
Preparado: Medio estéril, blanco; puede verse rosado cuando está caliente o antes de oxigenarse en placa.
CONTROL DE CRECIMIENTO (24–48 h a 37 °C o 21–28 °C)
| Microorganismo | Resultado esperado | Observaciones |
|---|---|---|
| Pseudomonas aeruginosa MKTA 27853 | Correcto | Colonias rojas en 24 h con fluorescencia verde-amarillenta a las 48 h. Recuento 92–99 % respecto a TSA estandarizado*, medio selectivo. |
| Burkholderia cepacia MKTA 25416 | Correcto | Colonias rojas sin fluorescencia. Recuento ≈72 % respecto a TSA estandarizado*, medio selectivo. |
| Staphylococcus aureus MKTA 6538P | Inhibido | Sin crecimiento. |
| Escherichia coli MKTA 25922 | Inhibido | Sin crecimiento. |
*TSA (Tryptic Soy Agar) estandarizado con recuperación ≥ 92–125 % respecto a cepas cuantitativas trazables a la cepa tipo.
NOTA TÉCNICA
Medio selectivo para Pseudomonas aeruginosa conforme a la Farmacopea USP XXI.
El cetil trimetil amonio bromuro (cetrimida), un compuesto de amonio cuaternario, inhibe la mayoría de la flora acompañante.
Este medio estimula la producción de fluoresceína y piocianina, y la mezcla cromogénica termoestabilizada permite una detección precoz en las primeras 24 horas, observándose pequeñas colonias rojas, que a las 48 horas presentan mayor tamaño y fluorescencia.
SIEMBRA E INTERPRETACIÓN DE RESULTADOS
-
Verter 20 ml de medio en cada placa de Petri estéril.
-
Dejar enfriar; el medio oxigenado recupera su color blanquecino.
-
Sembrar en superficie.
-
En el caso de placas de contacto, aplicar suavemente sobre la superficie sin mover.
-
-
Incubar a 37 ºC durante 18–48 horas.
Resultados esperados:
-
Pseudomonas aeruginosa forma colonias rojas rodeadas de fluorescencia verde-amarillenta, especialmente visible bajo luz UV de 366 nm (linterna MICROKIT VMT050).
-
Confirmar con:
-
Tiras de citocromo-oxidasa (KOT050) — usar exclusivamente asa de platino (VCS147).
-
Galerías de identificación bioquímica MICROKIT (ref. 245000).
-
PRESENTACIÓN
Medio deshidratado. Plaquis herméticas.
INFORMACIÓN ADICIONAL
Ficha técnica RAPID CETRIMIDE CROMOGENIC AGAR (PDF)
Versión CN RAPID para aguas envasadas
Correo: microkit@microkit.es
Prepárese para más de una sorpresa informativa cuando vea nuestro video sobre los medios Cromogénicos: https://www.youtube.com/watch?v=-JVPVWxY8ZE&t=271s